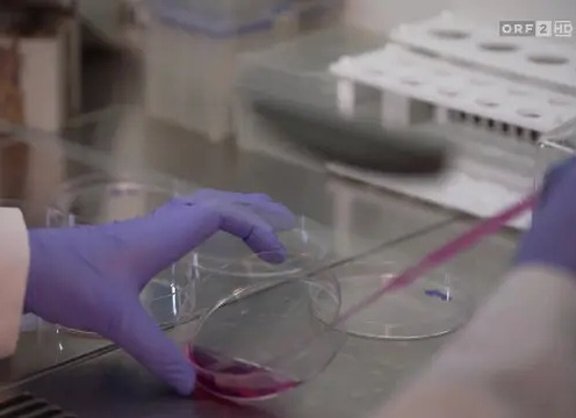
Thumbnail ORF

News und Events
Mai 2026
Frisches Förderprojekt am Institut
Wir freuen uns sehr, bekannt geben zu dürfen, dass Lena Guerrero Navarro eine Förderung im Rahmen der Tiroler Wissenschaftsförderung (TWF) erhalten hat. Ihr Projekt mit dem Titel „Modellierung chemotherapiebedingter Defekte der Hautregeneration bei Brustkrebs mithilfe von 2D-Fibroblasten-Kulturen und 3D-humanen Hautäquivalenten” startet am 1. Juni 2026. Wir gratulieren herzlich zu diesem großartigen Erfolg und wünschen viel Erfolg bei der Umsetzung!
April 2026
Rückblick: Lange Nacht der Forschung am IBA
Die Lange Nacht der Forschung 2026 war auch an unserem Institut ein lebendiger und gut besuchter Abend. Viele interessierte Besucher:innen nutzten die Gelegenheit für Austausch und Einblicke in unsere Arbeit.
Lange Nacht der Forschung 2026
Am 24. April 2026 ist es wieder so weit: Die Lange Nacht der Forschung lädt von 17:00 bis 23:00 Uhr zum Entdecken und Ausprobieren ein. Auch unser Institut ist heuer wieder mit vier spannenden Stationen vertreten und gibt Einblicke in aktuelle Forschungsbereiche. Vorbeischauen lohnt sich!
März 2026
MCI-Masterstudent am IBA
Wir freuen uns, Fabian Egger begrüßen zu dürfen! Als Masterstudent der Biotechnologie am MCI wird er seine Masterarbeit zum Thema Role of FAHD1 in Mitochondrial Metabolic Regulation and Structural Maturation of the Developing Mouse Heart unter der Betreuung von Athanasios Seretis in der Gruppe von Pidder Jansen-Dürr durchführen. Wir freuen uns, ihn am Institut willkommen zu heißen und wünschen ihm viel Erfolg für sein Forschungsprojekt.
Neue Masterstudentin
Wir begrüßen Meryem Kuzu herzlich als neue Masterstudentin am IBA! Sie wird ihre Masterarbeit zum Thema FAHD1 Deficiency and Its Impact on the Malate-Aspartate Shuttle and Mitochondrial Respiration unter der Betreuung von Athanasios Seretis in der Gruppe von Pidder Jansen-Dürr durchführen. Wir freuen uns, sie am Institut willkommen zu heißen und wünschen ihr viel Erfolg für ihr Forschungsprojekt!
Februar 2026
DC AGE_REG Winter School 2026
Am 4. und 5. Februar 2026 fand die AGE_REG Winter School im Agnes Heller Haus der Universität Innsbruck statt. An zwei Tagen wurden Vorträge, Trainingseinheiten und gemeinsame Sessions für die PhD-Studierenden angeboten, über Preise für die besten Poster und Kurzvorträge durften sich Elia Cappuccio, Amelie Schurer, Hooman Norouzi und Pauline Bicker freuen.
Januar 2026
Dezember 2025
Frisches Förderprojekt am Institut
Wir freuen uns sehr, bekanntgeben zu dürfen, dass Lena Guerrero Navarro im Rahmen der Ausschreibung „Early Stage Funding 2025 / 2. Tranche“ eine Förderzusage der Universität erhalten hat. Ihr Projekt “Multiscale evaluation of tattoo ink toxicity and senescence induction in human skin models” wurde von der Jury ausgewählt. Wir gratulieren herzlich zu diesem großartigen Erfolg und freuen uns auf die kommenden Entwicklungen!
November 2025
Oktober 2025
PhD Defensio
Wir gratulieren Max Holzknecht herzlich zum erfolgreichen Abschluss seiner PhD-Arbeit “The metabolic landscape of FAHD1 protective effects towards the growth of breast cancer cells and the development of cardiac disease”! Wir freuen uns mit ihm über diesen wichtigen Meilenstein und wünschen ihm alles Gute für die Zukunft.
Master Defensio
Herzlichen Glückwunsch an Matthias Scheppach zum erfolgreichen Abschluss seiner Masterarbeit mit dem Titel „Innovative in vivo Screening Platform to Identify Compounds Against UV-Induced and Oxidative Stress“! Wir freuen uns sehr über seinen Erfolg und wünschen ihm alles Gute für seine Zukunft!
ORF berichtet über Forschung am Institut
Im aktuellen ORF-Format „Mayrs Magazin – Wissen für alle“ wird das Thema „Hautsache Geschäft: Milliardenmarkt Anti-Aging“ behandelt. Der Beitrag stellt die Arbeit von Prof. Pidder Jansen-Dürr und seinem Team vor und bietet in kompakten vier Minuten einen Überblick über ihre Forschung zur biologischen Alterung der Haut.
Tiroler Nachwuchsforscher*innenförderung
Wir gratulieren Herrn Andreas Andric, MSc. herzlich zur Zusage der Tiroler Nachwuchsforscher*innenförderung. Die Unterstützung für das Projekt „FAHD1-Verlust in PCa: Stoffwechselanpassungen und gezielte Strategien“ ist eine wohlverdiente Anerkennung seiner Forschungsarbeit.
Juli 2025
DC AGE_REG Summer School 2025
Vom 2. bis 3. Juli 2025 fand auch in diesem Jahr wieder die DC AGE_REG Summer School statt. An zwei Tagen wurden Vorträge, Workshops und gemeinsame Sessions mit Expert:innen für die PhD-Studierenden im Agnes-Heller-Haus geboten. In Talks und Posterpräsentationen hatten die PhD-Studierenden zudem Gelegenheit, ihre Forschungsschwerpunkte und -fortschritte zu präsentieren.
Juni 2025
APOkongress 2025 in Pörtschach
Von 13. bis 15. Juni 2025 fand in Pörtschach am Wörthersee der APOkongress der Österreichischen Apothekerkammer zum Thema „Anti-Aging und Longevity“ statt. Univ.-Doz. Dr. Pidder Jansen-Dürr übernahm gemeinsam mit Mag. pharm. Susanne Ergott-Badawi die wissenschaftliche Leitung der ausgebuchten Fortbildungstagung mit über 350 Teilnehmenden.
Mai 2025
PhD Defensio
Herzlichen Glückwunsch an Lena Schreiberhuber (Forschungsgruppe Prof. Widschwendter) zur erfolgreich bestandenen PhD-Defensio zum Thema Epigenome-based risk prediction and detection of gynaecological cancers - wir freuen uns mit ihr über diesen großartigen Meilenstein und wünschen ihr für die Zukunft weiterhin viel Erfolg und alles Gute!
April 2025
Führung durch die Schindler-Villa
Zum Abschluss der dreitägigen Tagung Landhäuser und Gärten der Lebensreform. Im Kontext: Das Haus Schindler in Innsbruck fand am 04. April für die Referent:innen der Veranstaltung eine Führung von Institutsleiterin Birgit Weinberger und Pidder Janssen-Dürr durch unser Gebäude statt. Ermöglicht wurde die Tagung durch die philosophisch-historische Fakultät der Universität Innsbruck, das Vizerektorat für Forschung sowie die Fakultät für Architektur der Universität Innsbruck.
März 2025
Genehmigte FWF-Projekte
Wir gratulieren Assoz. Prof. Emmanuel Derudder, Dr., der vom FWF eine Förderung für sein 4-jähriges Principal Investigator Project erhalten hat, welches sich mit der Reaktion von B-Lymphozyten auf intrazelluläre Pathogene beschäftigt. Ebenfalls herzlichen Glückwunsch an William Olson, MSc PhD, dessen dreijähriges Projekt im Rahmen des Early-Stage Research-Innovation-Training (ESPRIT) Programms des FWF gefördert wird.
Februar 2025
DC AGE_REG Winter School 2025
Am 05. und 06. Februar 2025 fand die diesjährige Winter School des AGE_REG Doktoratsprogramms statt. Es gab einen regen Austausch zu Themen aus der Alternsforschung, der regenerativen Medizin und der Wirkstoffentwicklung, zudem erwartete die Studierenden ein spannender Mix aus Workshops, Poster Awards und einem hochkarätigen Gastvortrag.
Forschungspreis Stiftung Südtiroler Sparkasse an Ass.-Prof. Mag. Dr. Alexander Weiss
Die Universität Innsbruck vergibt seit 2008 im Namen der Stiftung Südtiroler Sparkasse den Wissenschaftspreis für außergewöhnliche Forschungsleistungen sowie den Forschungspreis für aktuelle Arbeiten an Wissenschaftler:innen der Universität Innsbruck. Die feierliche Verleihung der diesjährigen Preise fand am 3. Februar statt.
Wir gratulieren Herrn Ass.-Prof. Mag. Dr. Alexander Weiss herzlich zur Auszeichnung mit dem Forschungspreis und wünschen ihm weiterhin viel Erfolg bei seiner wertvollen Forschungsarbeit!
Juli 2024

Joint Summer School - DC AGE_REG & ARDRE
Am 03. und 04. Juli 2024 fand wieder eine Joint Summer School der Doktoratsprogramme AGE REG und ARDRE statt. Wie in den letzten Jahren gab es auch heuer wieder interessante Vorträge und Diskussionen aus den Bereichen Alternsforschung, regenerative Medizin und Wirkstoffentwicklung.
Juni 2024
Early Stage Funding 2024
Herzlichen Glückwunsch an einige unserer PhD Studierenden, dessen Projektanträge aus Mitteln des Early Stage Funding 2024 der Universität Innsbruck bewilligt wurden. Dies sind die Studierenden und ihre Projekte:
Victoria Strobl: Matrix metalloproteinases in modulating adipose stem cell proliferation during weight loss
Sonja Großmann: Role of autocrine-motility factor receptor in regulating adipose stem/progenitor cell growth
Periklis Ziakis: Enhancing miR-142 expression to boost the production of B cells
Elia Cappuccio: Loss of FAHD1 mediates mitochondrial dysfunction: Implications for cellular senescence
Lena Schreiberhuber: Performance of the WID-qCIN assay estimating risk of disease progression in cases of untreated high-grade precancerous lesions
März 2024

Feier zur Einweihung der neuen Institutsleitung
Zum 1. März 2024 übergibt Univ.-Doz. Dr. Pidder Jansen-Dürr die Aufgaben der Institutsleitung an Univ.-Prof. Dr. Birgit Weinberger. Dies wurde im Institut gefeiert.
Februar 2024

Joint Winter School - DC AGE_REG & ARDRE
Am 07. und 08. Februar 2024 fand wieder eine Joint Winter School der Doktoratsprogramme AGE REG und ARDRE statt. Wie in den letzten Jahren gab es auch heuer wieder interessante Vorträge und Diskussionen aus den Bereichen Alternsforschung, regenerative Medizin und Wirkstoffentwicklung.
September 2023
Early Stage Funding 2023
Herzlichen Glückwunsch an Gabriel Knoll, PhD-Student in der Forschungsgruppe Birgit Weinberger (Immunoseneszenz und Impfung), dessen Projektantrag „Phänotypische Charakterisierung regulatorischer CD8+T-Zellen im menschlichen Blut“ aus Mitteln des Early Stage Funding 2023 der Universität Innsbruck bewilligt wurde.
August 2023
Förderpreis der Tiroler Wissenschaftsförderung an Assoz. Prof. Dr. Emmanuel Derudder
Der Projektantrag mit dem Titel "Verminderung der B-Zell-Alterung durch miR-142s?" wurde von der Abt. Wirtschaftsstandort, Digitalisierung und Wissenschaft des Amtes der Tiroler Landesregierung im Rahmen der Tiroler Wissenschaftsförderung genehmigt.
Details dazu in der Pressemitteilung vom 14.8.2023.
Wir gratulieren Herrn Assoz. Prof. Dr. Emmanuel Derudder recht herzlich und wünschen ihm viel Erfolg bei seiner Forschungsarbeit!
Juli 2023
Förderpreis der Tiroler Wissenschaftsförderung an Ass. Prof. Dr. Alexander Weiss
Der Projektantrag mit dem Titel "FAHD1 als mögliches therapeutisches Ziel bei Brustkrebs" wurde von der Abt. Wirtschaftsstandort, Digitalisierung und Wissenschaft des Amtes der Tiroler Landesregierung im Rahmen der Tiroler Wissenschaftsförderung genehmigt.
Details dazu in der Pressemitteilung vom 29.7.2023.
Wir gratulieren Herrn Ass. Prof. Dr. Alexander Weiss recht herzlich und wünschen ihm viel Erfolg bei seiner Forschungsarbeit!
Juni 2023
Vorarlberger Wissenschaftspreis
Wir gratulieren Magdalena Hagen zum Erhalt eines Spezialpreises im Rahmen des Vorarlberger Wissenschaftspreises.